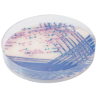
CHROMagar Salmonella Plus (5L)

Para la detección y aislamiento de especies de Salmonella incluyendo la Salmonella lactosa positiva
Tamaño: 5L
Este producto es sobre pedido, para mayor información envíe un correo a info@proventa.com.mx, llame al (81)-80-47-60-50 o póngase en contacto con cualquiera de las oficinas de Serco Comercial S.A. de C.V. en el país.